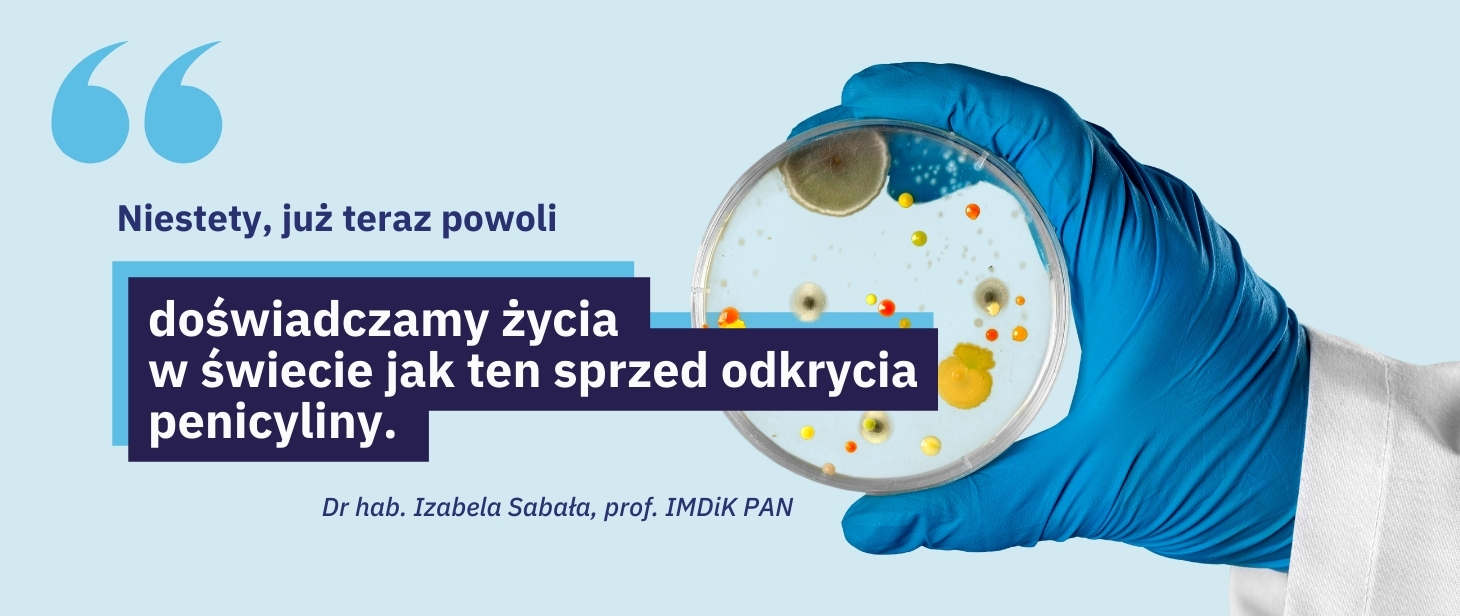

Polsko-norweski sojusz dla zdrowia. Historia jednego projektu
09.12.2024
Opracowanie technologii alternatywnej dla antybiotyków, mogącej znacząco przyczynić się do rozwiązania kryzysu antybiotykooporności. Ciekawe wyniki, część z nich już w druku.

Dwa zgłoszenia patentowe i materiały do pracy doktorskiej. Kontynuacja współpracy z partnerami z Norwegii. Sprecyzowane plany na przyszłość. To bezpośrednie efekty jednego tylko projektu zgłoszonego do Narodowego Centrum Badań i Rozwoju (NCBR) w Programie „Badania stosowane”. Projekt realizowany był w ramach Funduszy Norweskich. Choć pandemia COVID-19 usiłowała pokrzyżować te plany, innowatorzy stanęli na wysokości zadania i doprowadzili swoje prace do finału. Koniecznie przeczytajcie tę historię.
Kontakt z ludźmi, którzy stoją za nowatorskimi projektami, jest nie do przecenienia. Pokazuje drogę, którą dotąd przebyli. Odsłania ich pasje i marzenia. W kategorii marzycieli śmiało można umieścić dr hab. Izabelę Sabałę, profesor Instytutu Medycyny Doświadczalnej i Klinicznej im. M. Mossakowskiego Polskiej Akademii Nauk (IMDiK PAN).
Osoba, która nada ton tej opowieści, ukończyła biologię na Uniwersytecie Łódzkim oraz studia doktoranckie na Szwedzkim Uniwersytecie Rolniczym w Uppsali. Przyrodą interesowała się od zawsze.
– Zaczęło się od obserwacji i ciągłych pytań „dlaczego?”. W szkole moim ulubionym przedmiotem była oczywiście biologia, na studiach skupiłam się na biochemii i fizjologii, w trakcie doktoratu – na białkach. Teraz zajmuję się dogłębnym poznaniem jednej z grup białek, a konkretnie enzymów o właściwościach antybakteryjnych. Przeszłam więc swego rodzaju ewolucję zainteresowań, podążając od ogółu do szczegółu – mówi prof. Izabela Sabała.
Ale jedno się nie zmieniło. Wciąż stawia pytania „dlaczego?” i poszukuje na nie odpowiedzi. Za najważniejsze cechy swojego charakteru badaczka uważa dociekliwość i wytrwałość, bo jak wskazuje, bez nich trudno realizować marzenia, szczególnie te naukowe. W swojej pracy najbardziej ceni łączenie badań podstawowych z aplikacyjnymi.
– Z jednej strony, zajmujemy się badaniem białek, odkrywamy, jak są zbudowane, jak działają, jaka jest rola poszczególnych atomów. To pasjonujące móc zrozumieć, jak te miniaturowe maszyny wykonują swoje, czasami bardzo skomplikowane, zadania. Z drugiej strony, sprawdzamy, jak te same białka, a w naszym przypadku enzymy, wykorzystać. Czasami konieczne jest dostosowanie właściwości enzymów, tak aby działały w określonych warunkach. Udaje nam się to robić właśnie dlatego, że wcześniej poznaliśmy podstawy ich działania – tłumaczy.
Dwa płuca innowacji
Dziś kładzie się duży nacisk na innowacje, badania aplikacyjne, wręcz kwestionując przy tym sensowność prowadzenia badań podstawowych, które mają na celu poszerzenie wiedzy lub zrozumienia pewnych aspektów zjawisk. To błąd. Przedsięwzięcia, w które angażuje się prof. Izabela Sabała wraz z zespołem, dowodzą, że te dwa nurty badań są bezpośrednio połączone i że takie połączenie może dać pozytywne efekty. A jeśli do swoich pomysłów uda się zaangażować partnerów z zagranicy, szansa na sukces rośnie.
Ukończony w tym roku projekt PrevEco, zgłoszony do NCBR w konkursie POLNOR 2019 na wspólne polsko-norweskie projekty badawcze, jest tego doskonałym przykładem. IMDiK PAN pracował przy nim wspólnie z dwoma partnerami z Norwegii: Norwegian University of Life Sciences (NMBU) oraz firmą TINE SA, uzyskując blisko 6,6 mln zł dofinansowania z Programu „Badania stosowane” w ramach Norweskiego Mechanizmu Finansowego 2014-2021.
Narodowe Centrum Badań i Rozwoju, rządowa agencja łącząca świat nauki i biznesu, znane jest przede wszystkim z przyznawania grantów na realizację innowacyjnych projektów finansowanych z Funduszy Europejskich.
– Nieco mniej znaną, a wciąż rosnącą gałęzią naszej działalności jest uczestnictwo w licznych programach i inicjatywach międzynarodowych. Program „Badania stosowane”, który wdrażamy we współpracy z Norweską Radą Badań, stawia na podniesienie jakości badań aplikacyjnych w naszym kraju poprzez współpracę naukowo-badawczą między Polską a Norwegią. Projekt PrevEco doskonale pokazuje, jak obiecujące efekty może taka współpraca przynieść. Może stanie się dla kogoś inspiracją? – zauważa Agnieszka Ratajczak, dyrektor Działu Współpracy Międzynarodowej w NCBR.
Sposobów na znalezienie partnerów projektowych jest wiele. Mimo że zespół prof. Izabeli Sabały na co dzień współpracuje z wieloma badaczami z zagranicy, to jednak nie było wśród nich zespołów norweskich.
– Wiedzieliśmy, że w Norwegii są grupy, które zajmują się poszukiwaniem nowych substancji antybakteryjnych, a także firmy, które borykają się z problemami zakażeń bakteryjnych. Skontaktowaliśmy się z kilkoma potencjalnymi partnerami, mailowo przedstawiając propozycję współpracy. Odzew był bardzo pozytywny i przerósł nasze oczekiwania. Skończyło się na tym, że powstały dwa konsorcja, złożyliśmy dwa wnioski i otrzymaliśmy dwa granty. Ja kierowałam jednym z nich, liderem drugiego była dr Elżbieta Jagielska. Obydwa projekty dotyczyły opracowania alternatywnych nieantybiotykowych sposobów zwalczania bakterii – mówi prof. Izabela Sabała.
Kreatywność w parze z wytrwałością
Zespół, którego pracami kierowała prof. Sabała, skupił się na opracowaniu metod walki z infekcjami bakteryjnymi, wykorzystując do tego enzybiotyki i bakteriocyny, jednocześnie mając na celu ograniczenie stosowania antybiotyków u krów. W projekcie dr Elżbiety Jagielskiej, o akronimie SafeFoodCtrl, sprawdzane zaś były możliwości zastąpienia antybiotyków enzybiotykami w hodowli łososia norweskiego.
Nie ma gwarancji sukcesu. Dobry pomysł, wysoka wartość naukowa projektu i innowacyjność przygotowywanego rozwiązania to jeszcze nie wszystko. Ważna jest też determinacja. Jak już wiemy, wytrwałość to kluczowa cecha badaczki z IMDiK PAN. Nawet nie pomyślała, żeby się wycofać, gdy na początku realizacji projektu pojawiło się wiele małych problemów.
– Tak, początki nie były łatwe. Był rok 2020, środek pandemii, a my właśnie rozpoczynaliśmy koordynowanie dwóch dużych grantów z udziałem partnerów zagranicznych. Musieliśmy poszukać nowego miejsca na ich realizację. Oznaczało to zmianę promotora grantu, zorganizowanie i wyposażenie laboratorium, zatrudnienie nowych osób. A tu kwarantanny, zwolnienia, praca na zmiany, żeby zmniejszyć ryzyko zachorowania. To było olbrzymie wyzwanie dla całego zespołu. Dziś jestem dumna ze swoich współpracowników, ponieważ pomimo wszystkich tych przeciwności świetnie wywiązywali się ze swoich zadań. Dzięki ich zaangażowaniu wyszliśmy na prostą i zrealizowaliśmy wszystkie założenia – opowiada prof. Izabela Sabała.
Wszystko zaczęło się trochę przez przypadek
Zapytana, dlaczego postanowiła wydać walkę akurat oporności bakterii na antybiotyki, kierowniczka projektu PrevEco wyjaśnia, że to problem ważny i motywujący dla niej i całego zespołu. Natomiast praca nad enzybiotykami, czyli enzymami, które niszczą bakterie, trawiąc ich ściany komórkowe, zaczęła się wiele lat temu i właściwie przez przypadek. Poprzedziły ją badania podstawowe, których celem było poznanie struktury jednego z białek występujących w gronkowcu złocistym.
– Osiągnęliśmy nasz cel, a przy tym odkryliśmy, że fragment tego białka ma właściwości antybakteryjne. Tak zaczęła się nasza przygoda z enzybiotykami. Projekt PrevEco jest częścią tej drogi – mówi prof. Izabela Sabała. – Konkurs POLNOR ogłoszony przez NCBR doskonale pasował do naszego projektu. Mieliśmy już wstępnie opracowane enzybiotyki przeciwko gronkowcom. Wiedzieliśmy też, jak stworzyć nowe, które działają na inne szkodliwe bakterie. Jednak najważniejsze było dla nas sprawdzenie, jak to działa w praktyce. Chcieliśmy przekuć naszą teoretyczną wiedzę w coś użytecznego i potrzebnego – dodaje.
Jednym z największych problemów z antybiotykami jest ich nadmierne i niewłaściwe stosowanie. Prowadzi to do rozwoju oporności wśród bakterii. Mało kto wie, że ponad 70% wszystkich antybiotyków jest wykorzystywanych w rolnictwie. Jest to też jeden z powodów powstawania oporności.
– Pomysł na projekt PrevEco powstał na bazie tej wiedzy i doświadczenia. Zależało nam na sprawdzeniu, czy można używać enzybiotyków i bakteriocyn do walki z zakażeniami u zwierząt. Skupiliśmy się głównie na mastitis, czyli zakażeniu wymion u krów mlecznych. To bardzo duży problem w rolnictwie na całym świecie – wskazuje badaczka.
Nowe środki antybakteryjne – naturalna broń
W streszczeniu projektu znajdujemy stwierdzenie, że jeśli nie rozwiążemy problemu oporności na antybiotyki, wrócimy do czasów przed penicyliną. Jak wtedy wyglądałby świat?
– Niestety, już teraz powoli doświadczamy życia w świecie jak ten sprzed odkrycia penicyliny. Coraz więcej groźnych bakterii nie reaguje na dostępne antybiotyki – zwraca uwagę prof. Sabała. – W takich przypadkach lekarze nie mają czym leczyć pacjentów. Tak właśnie było przed wynalezieniem penicyliny.
Liczba zgonów spowodowanych opornością na antybiotyki już teraz budzi duże obawy. Według prognoz Światowej Organizacji Zdrowia (WHO), w 2050 roku może to być nawet 10 milionów zgonów rocznie. Tak będzie, jeżeli nikt nie znajdzie nowych skutecznych sposobów walki z bakteriami. WHO w ramach inicjatywy OneHealth podkreśla, że problem szerzenia się oporności można rozwiązać tylko globalnymi działaniami. Musimy jednocześnie dbać o zdrowie ludzi, środowiska i zwierząt.
Badacze z Polski i Norwegii chcą pokazać, że nie jest za późno na działanie. Pracują nad nowymi lekami, które będą skuteczne także przeciwko szczepom bakterii opornym na antybiotyki. Te nowe środki nie będą prowadzić do rozwoju oporności, tak jak to ma miejsce w przypadku tradycyjnych antybiotyków.
W projekcie PrevEco zaproponowano strategię, która zapobiega zakażeniom bakteryjnym oraz je leczy. Opiera się ona na enzybiotykach. Są to enzymy, które trawią ściany komórkowe bakterii, co prowadzi do ich zniszczenia i śmierci. Partnerzy norwescy pracują też nad wykorzystaniem w tym celu bakteriocyn. To peptydy produkowane przez bakterie, które eliminują inne bakterie w tej samej niszy. Prof. Sabała wyjaśnia, że to naturalna broń, którą bakterie wykorzystują do walki z konkurencją. Obie metody korzystają z substancji pochodzenia naturalnego.
– Nasze podejście ma unikalną cechę. Jest nią selektywność działania enzybiotyków. Potrafią one zwalczać tylko konkretne, patogenne bakterie. Nie wpływają przy tym na naturalną mikroflorę. To odróżnia nasze podejście od antybiotykoterapii. Naturalna, zrównoważona mikrobiota jest bardzo ważna dla zdrowia ludzi i zwierząt – podkreśla prof. Izabela Sabała.
Obiecujące wyniki testów
Celem projektu było opracowanie innych niż antybiotykowe sposobów zapobiegania zakażeniom bakteryjnym i leczenia ich. To pomogłoby ograniczyć stosowanie antybiotyków w rolnictwie. Badacze wierzą, że z czasem to podejście może okazać się pomocne także w medycynie, dając efekt ograniczenia oporności na antybiotyki. Wyniki badań są zachęcające. Co udało się do tej pory osiągnąć?
– Opracowaliśmy nowe enzymy i bakteriocyny, które działają na bakterie odpowiedzialne za mastitis u krów mlecznych oraz zakażenia ran. Zbadaliśmy ich działanie i opracowaliśmy metody produkcji. Przetestowaliśmy te substancje w laboratoriach – najpierw in vitro, a następnie na modelach zwierzęcych. Stworzyliśmy wstępne wersje produktów antybakteryjnych do higieny okołoudojowej. Potwierdziliśmy, że są skuteczne w testach polowych. Zbadaliśmy także, jak selektywne usuwanie szkodliwych bakterii wpływa na mikrobiotę – wylicza kierowniczka projektu. – Te wyniki napawają nas optymizmem.
Profesor Sabała mówi, że kiedy jej zespół odkrył swoje pierwsze enzymy antybakteryjne, trzeba było włożyć dużo wysiłku, aby dostosować ich właściwości do konkretnych warunków użycia. – W projekcie PrevEco udowodniliśmy, że możemy ten scenariusz odwrócić. To znaczy na początku założyć, jakie enzymy są potrzebne do danego zastosowania, jakie właściwości muszą posiadać – i wykorzystując nasze dotychczasowe doświadczenie, opracować takie enzymy naprawdę bardzo szybko. To jak „szycie” enzymów na zamówienie – wyjaśnia.
Kolejnym sukcesem było potwierdzenie pozytywnych wyników w testach polowych. To właśnie o to chodzi w projektach z obszaru badań stosowanych.
– Zakładaliśmy, że zastosowanie enzybiotyków w połączeniu z bakteriocynami pozwoli zapobiegać zakażeniom bakteryjnym u zwierząt i je leczyć , a także że nasze substancje będą skuteczne w usuwaniu szkodliwych bakterii i bezpieczne dla mikrobioty. Jednocześnie zależało nam na tym, żeby ich stosowanie nie wywoływało rozwoju oporności i było bezpieczne dla zwierząt i środowiska. Z badań wynika, że udało nam się to osiągnąć. W przyszłości powinno się to przełożyć na poprawę dobrostanu zwierząt, ograniczenie stosowania antybiotyków i zmniejszenie strat spowodowanych przez mastitis – podsumowuje.
Razem można więcej, czyli współpraca w projekcie
Przez pierwszy rok realizacji projektu każdy z partnerów miał swoje oddzielne zadania. IMDiK PAN pracował nad nowymi enzymami bakteriolitycznymi, zespół z NMBU badał bakteriocyny, a firma TINE prowadziła rozmowy z producentami mleka i zbierała od nich informacje.
Później współpraca została zacieśniona. – Badaliśmy, jak różne substancje mogą działać razem. Testowaliśmy je in vitro i na modelach zwierzęcych. Oba zespoły analizowały próbki z testów polowych. Dzięki temu mamy jasny obraz działania naszych substancji antybakteryjnych i wiemy, jak ich stosowanie oddziałuje na organizm, szczególnie na mikrobiotę. Wspólny cel pomógł nam połączyć naszą wiedzę i doświadczenia. To prowadziło do efektywnej pracy i uzyskania wyników, których żaden z partnerów nie byłby w stanie osiągnąć samodzielnie – tłumaczy prof. Sabała.
Współpraca między polskimi i norweskimi partnerami od początku układała się pomyślnie. Uczestnicy projektu z obu krajów potwierdzają, że do dziś nic się w tym zakresie nie zmieniło.
– Dużym wyzwaniem okazała się część administracyjna. Musieliśmy lepiej zrozumieć się nawzajem. Różnice wynikały z różnych doświadczeń i warunków pracy naukowców w Polsce i Norwegii. Na przykład poprosiłam o rozpisanie budżetu we wniosku o dofinansowanie. Dostałam odpowiedź zawartą w zaledwie trzech linijkach. Wynagrodzenia: kwota X, odczynniki: kwota Y, podróże: kwota Z. Brakowało bardziej szczegółowego opisu i uzasadnienia dla planowanych wydatków. Razem udało nam się dostosować ten budżet do wymogów NCBR. Pierwsza wersja raportu merytorycznego również była bardzo lakoniczna. Zawierała tylko kilka zdań, że wszystko idzie zgodnie z planem. Na koniec także w tej części dokumentacji forma opisu wyglądała tak, jak tego od nas wymagano – zaznacza kierowniczka projektu.
Partnerzy z Norwegii są zadowoleni z jakości wspólnych działań i komunikowania się w projekcie.
– W czasie realizacji projektu współpraca z laboratorium prof. Izabeli Sabały i NCBR była przyjazna i owocna. Dzięki połączeniu naszej wiedzy odkryliśmy unikalne połączenie substancji antybakteryjnych. Te środki pomagają w walce z zakażeniami wymion u bydła. Nasza współpraca trwa nadal. Szukamy teraz źródeł finansowania, aby dalej rozwijać opracowane środki – mówi prof. nadzw. Morten Kjos z uniwersytetu NMBU. Jest to uczelnia znana m.in. z innowacyjnych badań w dziedzinie zrównoważonego rolnictwa. – Projekt PrevEco rozszerzył także sieć kontaktów, użyteczną dla badaczy i studentów. Wszyscy uczestnicy zdobyli cenne doświadczenie w międzynarodowym projekcie badawczym opartym na współpracy – dodaje.
Håvard Nørstebø, szef działu B+R w TINE SA, chwali współpracę z polskim partnerem. – Zarządzanie projektem było profesjonalne. Nasi polscy koledzy mieli dużą wiedzę i wykazywali zaangażowanie. To znacznie podniosło jakość naszej pracy. Dziękuję również za pomoc Narodowemu Centrum Badań i Rozwoju – mówi.
TINE SA to największy gracz na norweskim rynku produktów mleczarskich. Misją firmy jest dostarczanie konsumentom zdrowej żywności. Zaangażowanie w projekt PrevEco to kolejny etap w realizacji tego celu.
Członkowie konsorcjum badawczego regularnie wymieniali maile i rozmawiali on-line. Z powodu pandemii pierwsze osobiste spotkanie odbyło się dopiero w połowie projektu. Na żywo widzieli się w sumie trzy razy: dwukrotnie w Polsce i raz w Norwegii. Uczestnicy zgodnie mówią, że były to bardzo potrzebne spotkania.
Kto odniesie korzyści z wyników projektu?
Działanie w konsorcjach to dla innowatorów świetny sposób na zdobycie nowej wiedzy i lepsze zrozumienie problemów. Pozwala na uzyskanie wyników, które dają pełniejsze zrozumienie badanego problemu. Przekłada się to także na wartościowe publikacje, zbudowanie międzynarodowej reputacji, a nierzadko – przyjaźnie na całe życie.
Wykonawcy projektu już odnoszą wiele korzyści. Zebrali ciekawe wyniki. Część z nich opublikowali, a inne są w drodze do publikacji. Złożyli dwa zgłoszenia patentowe i zebrali materiały do doktoratu. Wspólnie analizują wyniki i planują dalszą współpracę. Mają wiele nowych pomysłów na przyszłość.
– Cenię naszą współpracę i perspektywy jej kontynuacji w celu opracowania nowych metod walki z bakteriami. Chcielibyśmy dzięki naszym badaniom przyczynić się do ograniczenia antybiotykooporności, poprawy jakość żywności oraz obniżenia kosztów jest produkcji. Nie mam wątpliwości, że te zmiany będą korzystne dla wszystkich. Wciąż potrzeba dużo wysiłku i dalszych inwestycji, by wprowadzić naszą technologię na rynek. Jednak wierzymy, że to marzenie się spełni – podsumowuje prof. Izabela Sabała.
Fundusze Norweskie i EOG od lat pozwalają rozwijać międzynarodową współpracę na polu nauki. Realizowany przez NCBR program ma na celu podniesienie jakości badań stosowanych w naszym kraju poprzez wzmocnienie współpracy naukowo-badawczej między Polską a Norwegią, opartej na partnerstwie między organizacjami badawczymi i przedsiębiorstwami z obu państw.
Do tej pory wsparcie uzyskało 1649 naukowców, którzy dzięki programowi mogli rozwijać swoje badania w takich obszarach, jak: zdrowie, cyfryzacja, klimat i energetyka. 139 instytucji uzyskało dostęp do finansowania i możliwości międzynarodowej współpracy. 81 projektów zakończyło się sukcesem. Owocem tej pracy jest też 710 recenzowanych publikacji naukowych, w tym 189 wspólnych prac polsko-norweskich.
Obecna perspektywa kończy się w kwietniu 2025 roku. Ustalenia w sprawie nowego programu finansowanego z Funduszy Norweskich i EOG powinny zapaść już niebawem.
Chcesz być na bieżąco z ofertą NCBR dla innowatorów?
Dołącz do grona odbiorców naszego newslettera. zapisz się